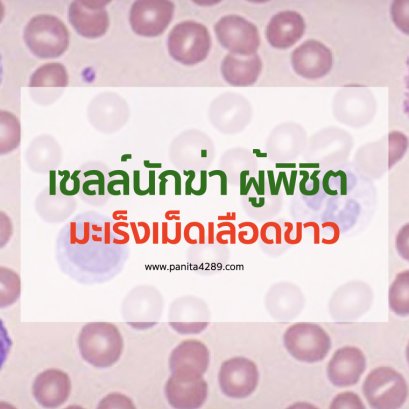
มะเร็งเม็ดเลือดขาว

CONTENT
อัมพฤกษ์ อัมพาต เป็นโรคที่สามารถเกิดได้ในทุกเพศทุกวัย หากเป็นแล้วจะทำให้เกิดอาการแขนขาอ่อนแรง ขยับตัวไม่ได้ เสี่ยงต่อการเป็นผู้ป่วยติดเตียง
อาการเส้นเลือดในสมองแตก ปัจจัยเสี่ยงของโรคหลอดเลือดสมอง (Stroke) เนื่องจากการอุดตันของหลอดเลือด ทำให้เลือดไม่สามารถไหลเวียนไปเลี้ยงยังสมองได้
โปรไบโอติกส์ เป็นจุลินทรีย์ที่มีชีวิตก่อให้เกิดประโยชน์ต่อสุขภาพ ช่วยกระตุ้นการทำงานของภูมิคุ้มกัน และปรับสมดุลของจุลินทรีย์ในร่างกาย
เรสเวอราทรอล เป็นสารช่วยกำจัดอนุมูลอิสระออกจากเซลล์และเนื้อเยื่อ ได้อย่างมีประสิทธิภาพ จะปกป้องร่างกายโดยการจับและกำจัดอนุมูลอิสระทิ้งออกจากเซลล์
ภาวะลิ่มเลือดอุดตัน ภัยเงียบที่ไม่ควรมองข้าม ประชากรทั่วโลก เสียชีวิตจากภาวะหลอดเลือดอุดตัน พบผู้ป่วยภาวะลิ่มเลือดอุดตันเพิ่มขึ้นอย่างต่อเนื่อง
HPV ไวรัสใกล้ตัวที่น่ากลัวกว่าที่คิด ประเทศไทยมีผู้หญิงที่เสียชีวิตจากมะเร็งปากมดลูก ถือว่าเป็นภัยเงียบที่อันตรายสำหรับทั้งเพศชายและหญิง
8 สัญญาณเตือนเบาหวาน ภัยเงียบที่เป็นต้นตอของอีกหลายโรคตามมา เราอาจจะเป็นคนหนึ่งที่อยู่ในกลุ่มเสี่ยงเป็นเบาหวาน ซึ่งผู้ป่วยเบาหวานพุ่งสูงขึ้นทั่วโลก
การรับประทานอาหารที่หลากหลายและสมดุลเป็นสิ่งสำคัญในการที่ร่างกายได้รับวิตามินซี และ แร่ธาตุต่างๆ ที่เพียงพอต่อความต้องการของร่างกาย
"มะเร็งต่อมน้ำเหลือง" รู้เร็วรักษาหาย เช็กสัญญาณเตือน พบคนไทยป่วย 3,000 - 4,000 คนต่อปี แนะวิธีสังเกตสัญญาณเตือน อาการแบบไหนควรรีบไปพบแพทย์
มะเร็งต่อมลูกหมาก เป็นมะเร็งที่พบเป็นอันดับต้นๆในผู้ชายไทย โดยอาการที่เป็นสัญญาณเตือนถึงความเป็นไปได้ว่า จะเป็นโรคมะเร็งต่อมลูกหมาก
ไฟเบอร์ ( Fiber ) ทำงานอย่างไรในร่างกายของเรา ไฟเบอร์ หรือ ใยอาหาร มีชื่อหนึ่งคือ เซลลูโลส ที่เราสามารถพบได้ในอาหารจำพวกผัก ผลไม้และธัญพืช
8 สัญญาณเตือน มะเร็งปากมดลูก สาเหตุของการเสียชีวิตอันดับต้นๆ ของผู้หญิงไทย โดยพบได้ตั้งแต่ผู้หญิงอายุก่อน 30 ปี มักพบในช่วงอายุระหว่าง 35 – 50 ปี
เซลล์นักฆ่า ผู้พิชิตมะเร็งเม็ดเลือดขาว เป็นโรคมะเร็งที่เกิดขึ้นในไขกระดูก เกิดจากมีเซลล์เม็ดเลือดขาวตัวอ่อนเติบโตมากผิดปกติโดยไม่ทราบสาเหตุ
3 สาเหตุหลักของ มะเร็งปอด สาเหตุที่ทำให้เกิดมะเร็งปอดอาจไม่ใช่แค่การสูบบุหรี่เท่านั้น....โรคมะเร็งปอดมักจะพบในเพศชายมากกว่าเพศหญิง
8 วิธีลดเสี่ยงมะเร็งตับ สาเหตุของการเสียชีวิต และเจ็บป่วยเรื้อรังจนเป็นสาเหตุการตายก่อนวัยอันสมควร มะเร็งตับหากเป็นแล้ว รักษาได้ และมีโอกาสหายขาด
9 เคล็ดลับสู่อาหารต้านมะเร็ง สาเหตุการเสียชีวิตอันดับหนึ่งของคนไทยต่อเนื่อง จากการศึกษาพบว่าอาหารมีส่วนสัมพันธ์กับการเกิดโรคมะเร็งประมาณ 30 - 50%
ปัจจัยเสี่ยงของโรคมะเร็งเต้านม พบมากที่สุดในผู้หญิง จากสถิติของสถาบันมะเร็งแห่งชาติพบผู้หญิงเป็นมะเร็งเต้านมร้อยละ 37 ของมะเร็งทั้งหมด
มะเร็งลำไส้ รู้เร็ว รักษาได้ ภัยร้ายใกล้ตัว ที่ไม่ควรมองข้าม เช็คด่วน อาการเสี่ยงมะเร็งลำใส้ใหญ่ สังเกตอาการของตัวเองด่วนๆ
8 คุณประโยชน์จากงานวิจัยสารสกัดเซซามิน & EGCG การผสานสารสกัดสำคัญในชาเขียว แอนโธซัยยานินส์ รำข้าวสีนิล และแป้งข้าวหอมมะลิ ที่มีคุณประโยชน์ต่อสุขภาพ
งาดำ เป็นธัญพืชที่มีผู้ใช้เป็นอาหารมากกว่า 4,000 ปี คุณประโยชน์ของสารสกัดเซซามิน จากงาดำ จากการศึกษาวิจัย ได้พบว่าเป็นอาหารที่ทรงคุณค่าทางโภชนาการมาก
ภาวะกระทุ้งพิษ หรือ ปฏิกิริยาตอบสนอง ต่อร่างกายต่อการปรับสมดุลย์ในร่างกาย อาจมีการตอบสนองของร่างกายที่นำไปสู่ความสมดุลย์ และสุขภาพที่ดีปฏิกิริยาต่างๆ